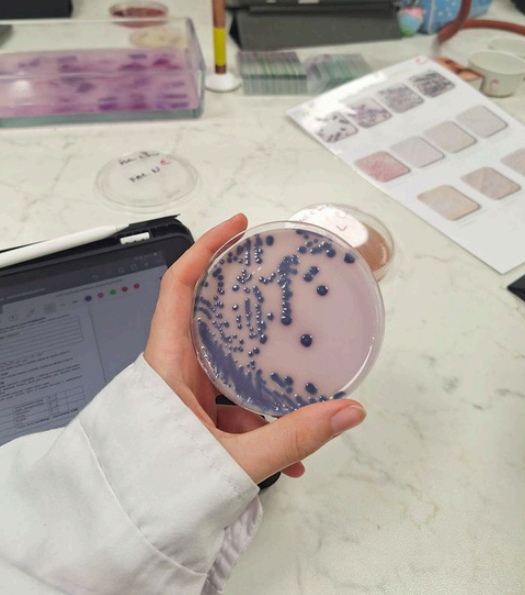

Empowering Women’s Health

A non-profit organization dedicated to supporting healthcare and biomedical research companies that focus specifically on women’s health issues.
Our Journey, Our Mission
At just 16 years old, our founder was diagnosed with PolyCystic Ovarian Syndrome, a condition that affects 1 in 10 women worldwide. This personal journey through a broken healthcare system, especially for young women of color and low income, inspired the creation of Artemis Biomedical Research Fund. We raise funds to support research to help women understand their health and for underfunded women’s health issues. At Artemis Biomedical Research Fund, we believe that every woman deserves to be heard, healthy, and have access to the healthcare she needs, no matter her circumstances.
Our Impact
what we do
We are committed to bettering women’s health across the globe through various initiatives.

Merchandise
Support our cause and spread awareness with our range of merchandise.

Donations
Your generous donations help us fund vital research and support services.

Memberships
Join us and become a part of our mission to empower women’s health.

Special Events
Participate in our events aimed at raising funds and spreading awareness.

Partnerships
Collaborate with us and make a difference in women’s health.
What Sets Us Apart
We are dedicated to a niche cause – to improve women’s health across the globe.

Personal Experience
Our foundation is rooted in personal experience, giving us unique insight into the challenges faced by women.

Focused Mission
We are dedicated to supporting underfunded women’s health issues.

Community Impact
We strive to make a difference in the communities of women around us.


Contact Us!

Email: artemisbiomedicalfund@gmail.com

Phone: 704-968-2943

Business Hours: 6:30 AM – 4:30 PM
